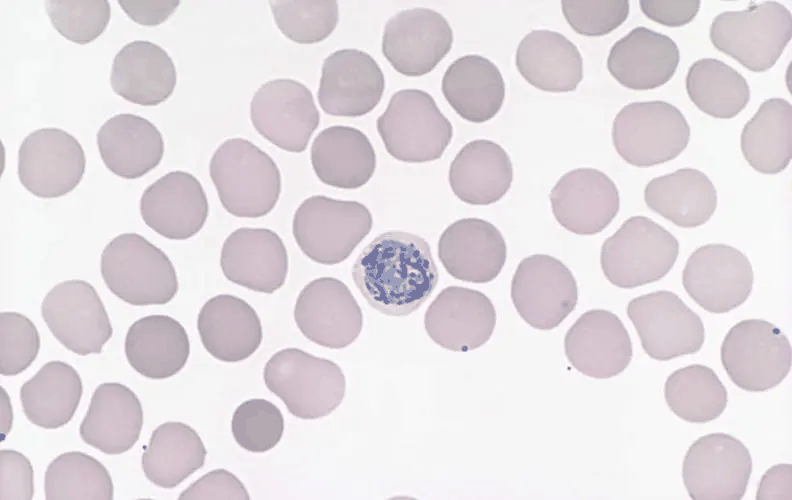
原生细胞

原初生命体
目录
简介
原生细胞(或原生细胞)是一种自组织的、内生有序的、球形的脂质集合体,被认为是走向生命起源的垫脚石。
进化的一个核心问题是简单的原生细胞首先是如何出现的,以及它们在生殖输出方面的差异,以便随着时间的推移出现新生物的积累,即生物进化。
尽管在实验室环境中还没有实现功能性原生质体,但了解这一过程的目标似乎已经指日可待。
概述
分区化在生命的起源中很重要。膜形成了与外部环境分离的封闭隔间,从而为细胞提供了功能上的专门水空间。由于膜的脂质双分子层对大多数亲水分子(被水溶解)是不可渗透的,所以细胞有一个膜运输系统,能够输入营养分子,也能输出废物。
从分子组合中构建本地细胞是非常具有挑战性的。这一挑战的一个重要步骤是使用两亲分子来实现与细胞功能相关的囊泡动力学,如膜贩运和自我繁殖。
在原始的地球上,众多有机化合物的化学反应产生了生命的组成部分。在这些物质中,两亲分子可能是生命从分子组装到细胞生命进化过程中的第 一批参与者。
从囊泡到原生质体的一个步骤可能是发展出与新陈代谢系统相结合的自我繁殖的囊泡。
原生质体概念的另一种方法涉及chemoton(化学自动机的简称),它是指匈牙利理论生物学家Tibor Gánti提出的生命基本单位的抽象模型。它是已知的最古老的原细胞的计算抽象。
甘蒂于1952年构思了这一基本概念,并于1971年在他的《生命原理》一书中提出。他推测,化子是所有生物的原始祖先,或者说是最后的普遍共同祖先。
化子模型的基本假设是,生命在根本上和本质上应该有三个特性:新陈代谢、自我复制和双脂膜。
新陈代谢和复制共同构成了生命基本功能所必需的自催化子系统,而膜围绕着这个子系统,将其与周围环境分开。因此,任何具有这种特性的系统都可以被看作是有生命的,它将受到自然选择的影响,并包含一个自我维持的细胞信息。
有些人认为这个模型是对生命起源的一个重要贡献,因为它提供了一个进化单位的哲学。
分离的选择性
自组装的囊泡是原始细胞的一个基本组成部分。热力学第二定律要求宇宙朝着无序(或熵)增加的方向发展,然而生命因其巨大的组织程度而与众不同。
因此,需要一个边界,将生命过程与非生命物质分开。细胞膜是在地球上所有生物的所有细胞中发现的xxx细胞结构。
在已知所有细胞都在其中运作的水环境中,需要一个非水的屏障来包围细胞并将其与周围环境分开。为了成为一个实体并与环境区分开来,需要一个自由扩散的屏障。
隔离一个子系统的热力学必要性是生命的一个不可减少的条件。这种隔离通常是通过膜来完成的,即大约10-8米厚的两亲分子双层膜。
包括Irene A. Chen和Jack W. Szostak在内的研究人员已经表明,基本初级细胞的简单物理化学特性可以产生基本细胞行为的更简单的概念类似物,包括原始形式的达尔文竞争和能量储存。
膜和被包裹的内容物之间的这种合作互动可以大 大简化从复制分子到真正细胞的过渡。对膜分子的竞争将有利于稳定的膜,这表明交联脂肪酸甚至今天的磷脂的进化有选择优势。这种微囊化允许在膜内进行新陈代谢,交换小分子,防止大物质穿过膜。
封装的主要优点包括增加货物的溶解度和以化学梯度的形式创造能量。